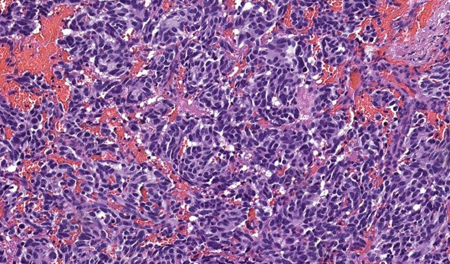
blog_img

Integrated treatment plans addressing cancer alongside existing chronic illnesses.
Expert care for uncommon malignancies requiring specialized treatment strategies.

Management of atypical cancer patterns with individualized treatment planning.

Carefully balanced cancer treatment ensuring safety of both mother and fetus.

Inclusive, respectful cancer care addressing unique medical and psychosocial needs.

Age-specific oncology care focusing on fertility, survivorship, and quality of life.

Tailored cancer treatment considering age, comorbidities, and functional status.

Safe oncology care for patients with weakened immune systems.
